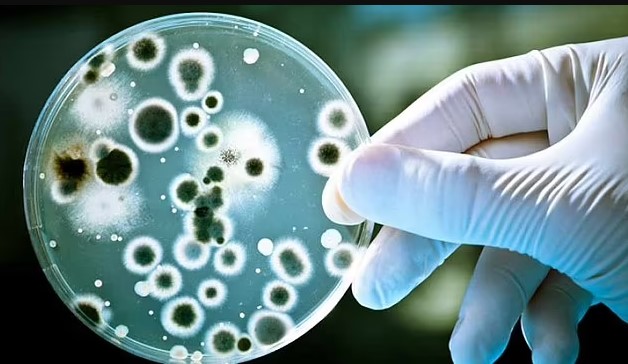

Плагин-гибриды: стоит ли платить больше за экологичность и экономию
Автомобили-гибриды типа Plug-in - самые гибридные среди всех гибридов, а в некоторых странах PHEV вообще считаются "электричками". Почему они такие особенные и главное, стоят ли их возможности их большей цены? rbc.ua »